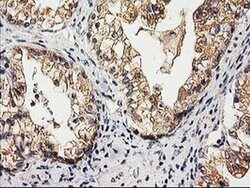
CHCHD5 Monoclonal Antibody (OTI9E6):Antibodies, Monoclonal
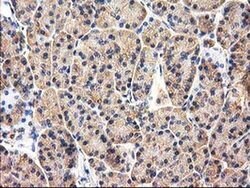
CHCHD5 Monoclonal Antibody (OTI9E6):Antibodies, Monoclonal

Promotional price valid on web orders only. Your contract pricing may differ. Interested in signing up for a dedicated account number?
Learn More
Learn More
CHCHD5 Monoclonal Antibody (OTI9E6)


CHCHD5 Monoclonal Antibody (OTI9E6)
Supplier: Thermo Scientific MA525416
Description

Specifications
| CHCHD5 | |
| Monoclonal | |
| 0.62 mg/mL | |
| PBS with 1% BSA, 50% glycerol and 0.02% sodium azide; pH 7.3 | |
| Q9BSY4 | |
| CHCHD5 | |
| Full length human recombinant protein of CHCHD5 produced in E.coli. | |
| 100 μL | |
| Primary | |
| Human | |
| Antibody | |
| IgG1 |
| Flow Cytometry, Immunohistochemistry (Paraffin), Western Blot | |
| OTI9E6 | |
| Unconjugated | |
| CHCHD5 | |
| 1110027L01Rik; AW045710; C2orf9; Chchd5; coiled-coil-helix-coiled-coil-helix domain containing 5; coiled-coil-helix-coiled-coil-helix domain-containing protein 5; MIC14; mitochondrial intermembrane space cysteine motif protein of 14 kDa homolog | |
| Mouse | |
| Affinity Chromatography | |
| RUO | |
| 84269 | |
| -20°C, Avoid Freeze/Thaw Cycles | |
| Liquid |
Product Content Correction
Your input is important to us. Please complete this form to provide feedback related to the content on this product.
Product Title
Spot an opportunity for improvement?Share a Content Correction